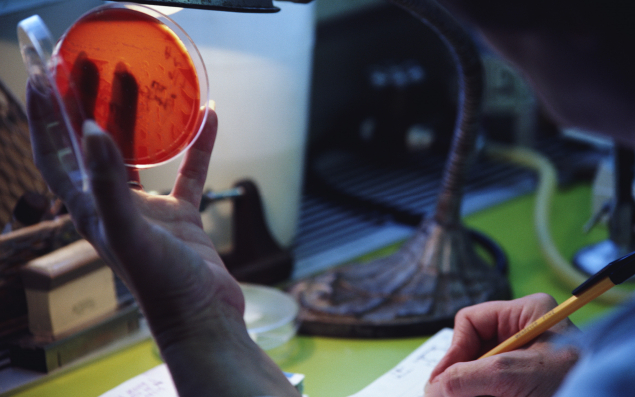

«En juin 2006, après un chute vertigineuse, j'ai accepté de prendre la présidence de l'Adria et de lancer un plan de redressement en concertation avec ses salariés, se souvient Jean Le Lez. C'était un défi de reprendre ce site créé par les industriels, pour les industriels. En dix ans, nous avons su construire prudemment une entreprise qui marche.»
Ascension prudente mais payante
L'Adria, installé à Quimper est en effet passé d'un chiffre d'affaires de 2,7 M€ en 2006, à 5 M€ cette année. Et compte 500 clients à travers le monde (36% du CA se fait en Bretagne, 47% en France, 12% en UE et 5% aux USA), et 120 adhérents, pour la plupart des entreprises de l'agroalimentaire et des entités publiques. Cette résurrection s'est d'ailleurs faite avec le soutien de l'Etat et des collectivités territoriales qui ne souhaitaient pas perdre un tel niveau d'expertise, notamment en biochimie, pour une région dont l'agroalimentaire est un fer de lance économique. Mais il aura fallu aussi convaincre les clients, à 78% issus du secteur privé, des atouts d'un tel outil. Aujourd'hui l'institut vend près de 300 conseils par an aux entreprises et forme 5 000 personnes par an.
Objectif 2021: 25% de croissance
«Nous souhaitons devenir un institut technique de référence en Europe» annonce Jean Le Lez. Pour ce faire, l'Adria va développer son volet e-learning, proposer des formations certifiantes, et augmenter sa partie conseil et audit.
Deux millions d’euros seront investis dans l’extension de 800 m² de ses laboratoires, qui ira de paire avec l’embauche d’une quinzaine de chercheurs d’ici à 2021, pour passer ainsi de 60 à 75 salariés.
Développer l'innovation
«Les équipes se sont projetées dans le futur, pour anticiper ce qui impactera demain le secteur agro-alimentaire. Vu le contexte concurrentiel, on s'est bien jaugé avant de lancer un business plan sur cinq ans. Un de nos points forts étant la Validation des Méthodes Rapides» confie Daniel Sauvaget, président de la société Ecomiam et membre de l'Adria.
Sans vouloir dévoiler ses cartes, Jean-Robert Geoffroy de l'Adria réplique: «Le domaine de la recherche est très observé, nous réservons nos innovations à notre territoire, mais dans les grandes lignes nous restons sur la microbiologie, notre cœur de métier, en tentant d'améliorer la conservation des aliments, les process alimentaires, la recherche protéinique, la végétalisation et la diminution des intrants dans la production agricole».